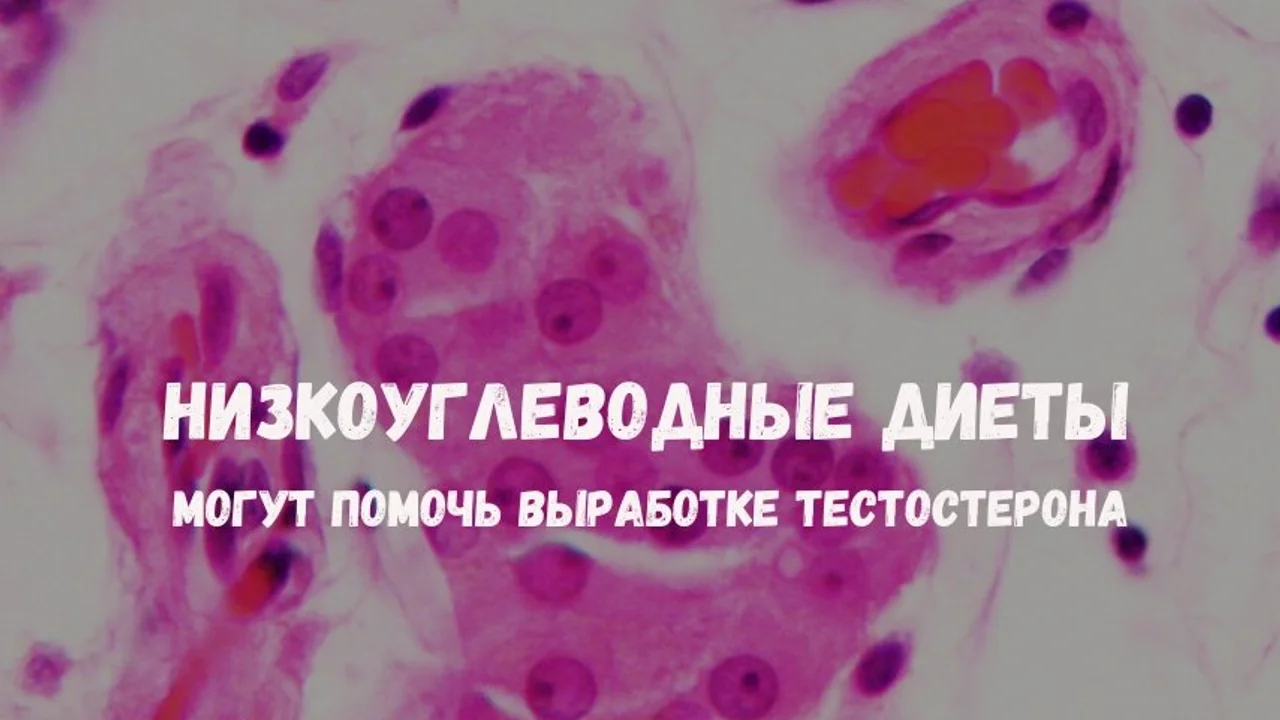
Низкоуглеводные диеты могут помочь выработке тестостерона

9 ноября 2024
Тестостерон - это стероид, анаболический гормон, вырабатываемый яичками и яичниками. В яичках есть особые клетки, называемые клетками Лейдига, которые являются основными производящими клетками тестостерона у мужчин.
Холестерин является предшественником тестостерона и начинает вырабатываться, когда холестерин попадает в митохондрии клеток Лейдига. Существуют метаболиты тестостерона и менее полезные/биологически активные формы тестостерона, которые могут быть изменены с помощью определенных ферментов, которые ингибируют или отклоняют выработку тестостерона. Например, фермент ароматаза, содержащийся в жировой ткани, может превращать тестостерон в эстрадиол.
Выработка тестостерона управляется цепочкой сигналов между мозгом и яичками. Всё начинается с того, что гипоталамус (часть мозга) вырабатывает гормон, который даёт команду гипофизу (другой участок мозга) выпустить два других гормона – ЛГ (лютеинизирующий) и ФСГ (фолликулостимулирующий). Эти гормоны отправляются к яичкам, где ЛГ стимулирует клетки, чтобы те начали производить тестостерон.
Когда уровень тестостерона в крови становится достаточно высоким, он посылает сигнал обратно в мозг, чтобы замедлить выработку командных гормонов. Это как система обратной связи: если тестостерона слишком много, мозг снижает его производство, чтобы не было избытка.
Ожирение и метаболический синдром тесно связаны с низким уровнем тестостерона, этот мета-анализ (*) показывает, что как метаболический синдром, так и диабет независимо друг от друга связаны с низкой выработкой тестостерона. Другие исследования подтвердили эти выводы.

Другой недавний мета-анализ продемонстрировал связь между диетами с низким содержанием жиров и низким уровнем тестостерона (*). Многие интервенционные исследования диетических вмешательств показали аналогичные результаты, что низкое содержание жиров может отрицательно сказываться на уровне тестостерона у мужчин (*).
Исследования показывают, что снижение потребления насыщенных жиров может уменьшить уровни андрогенов, таких как андростендион и тестостерон, а также свободного тестостерона в крови. Это связано с тем, что насыщенные жиры влияют на гормональные механизмы, участвующие в их синтезе и метаболизме. Переход на низкожировую диету может снизить активность биохимических путей, которые регулируют выработку андрогенов, что приводит к падению их концентраций
Разбор под ваш профиль, а не под среднюю статистику
Собираем образовательную линию материалов по вашим целям, анализам и текущим вопросам: метаболизм, сон, воспаление, энергия.
Другое контролируемое исследование показало заметное повышение уровня тестостерона при соблюдении диеты с высоким содержанием жиров и низким содержанием клетчатки и показало, что уровень тестостерона снижается при уменьшении количества жира и увеличении количества клетчатки (*). Очень похожие результаты были продемонстрированы в этом исследовании (*).
На помощь приходит низкоуглеводная диета

Важно отметить, что низкоуглеводные/кето-диеты, по-видимому, не оказывают такого негативного влияния на уровень тестостерона. Согласно метаанализу, диеты с низким содержанием углеводов и высоким содержанием жиров, повышают уровень тестостерона (*) Интересно, что исследование показало, что диеты с высоким содержанием белка и низким содержанием жиров могут снижать уровень тестостерона.
Недавнее экспериментальное исследование показало, что даже очень низкокалорийная диета с высоким содержанием жиров может поддерживать или повышать уровень тестостерона (*)
Чтобы выявить низкий уровень тестостерона, можно провести несколько анализов крови.
* анализ свободного и общего тестостерона;
* анализ ГСПГ (глобулина, связывающего половые гормоны);
* анализ биодоступного тестостерона.
Однако, как уже упоминалось ранее, уровень тестостерона регулируется не только половыми железами, но и другими органами, а также зависит от ряда факторов и ферментов. Поэтому очень важно также обратить внимание на первичные и вторичные причины, влияющие на уровень тестостерона.
Обычно проверяем уровни липидов, ЛПНП, инсулина, ТТГ, пролактина, эстрадиола, глюкозы, фолиевой кислоты, витамина B12, витамина D3 и некоторых других веществ.
Глубокие разборы без случайной ленты
Архив премиум-статей: механизмы, исследования, схемы и практические выводы по метаболическому здоровью.
Важно учитывать как метаболический синдром, так и факторы, связанные с плохим питанием, а также уровни других гормонов. В конечном итоге, для диагностики «низкого уровня тестостерона» необходимо учитывать как симптомы, так и результаты лабораторных исследований.
Кроме того, я бы не стал полностью полагаться на современные показатели, которые считаются «нормальными» в лабораториях.
Те же принципы применимы к уровням глюкозы, триглицеридов и витамина D.
В конечном счете, прежде чем приступить к фармакологическому лечению, стоит изменить диету и образ жизни. Мы наблюдали, как уровень тестостерона значительно повышался за пару месяцев без какого-либо вмешательства, просто употребляя стейки и яйца.

Cуществует два основных общепринятых подхода к лечению:
ЗТТ (заместительная терапия тестостероном) и кломифен (Клостилбегит).
Оба метода могут привести к значительным положительным изменениям в психическом, физическом и сексуальном здоровье. ЗТТ и кломифен являются хорошими вариантами с небольшими рисками и побочными эффектами, которые стоит рассмотреть.
Существуют и другие соображения, такие как использование трансдермального метода или инъекций, но это выходит за рамки данной статьи. Кроме того, прием тестостерона также может быть полезен женщинам с гипосексуальностью. Обычно доза минимальна, примерно 1/10-1/20 от той, которая обычно необходима мужчинам.
Итоги:
Можно обратить вспять ожирение, метаболический синдром и инсулинорезистентность, и многие люди смогут избежать необходимости в лечении. Однако не стоит отказываться от терапии, поскольку ЗТТ и кломифен способны значительно улучшить качество жизни пациентов мужского пола.